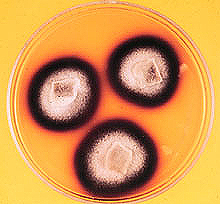

APARATELE VEGETATIVE ALE CIUPERCILOR
Ciupercile sunt organisme heterotrofe care au un aparat vegetativ numit tal, lipsit de clorofila sau alt pigment asimilator.
In general, talul ciupercilor este numit miceliu, dar in functie de constitutia sa pot fi diferentiate mai multe tipuri. Cel mai simplu tip de aparat vegetativ poarta numele de gimnoplast iar cel mai evoluat este talul masiv.
a) Gimnoplastul este constituit din citoplasma si nucleu.. Deoarece este lipsit de o membrana proprie, giamnoplastul nu are o forma precisa. De regula gimnoplastul unei ciuperci parazite traieste intracelular luand forma celulei parazitate. Acest tip de aparat vegetativ este intalnit la ciupercile inferioare din clasa Ascomycetes-Synchitrium endobioticum (fig. 22).


Fig. 22 Gimnoplast - Synchytrium endobioticum
b) Plasmodiul este reprezentat de o masa da citoplasma in care se afla mai multi nuclei. Plasmodiul are forma variabila, ca si gimnoplastul, fiind lipsit de membrana. Plasamodiul este prezent la ciupercile din familia Plasmodiophoraceae, clasa Ascomycetes. Intr-o sectiune efectuata prin radacina de varza atacata de Plasmodiophora brassicae se observa celule gigantice pline cu plasmodii sporulate(fig. 22).


Fig. 23 - Plasmodiu- Plasmodiophora brassicae
c) Dermatoplastul se prezinta ca o celula tipica, cu toate elementele constitutive: membrana, citoplasma si nucleu. Prezenta membranei imprima dermatoplastului o forma fixa. Dermatoplastul se intalneste la ciupercile inferioare din clasa Phycomycetes si Ascomycetes. Uneori dormatoplastii inmuguresc si formeaza coenobii, mai ales la suprafata mediilor lichide ( ex. Saccharomyces cerevisiae-fig. 24).


Fig. 24 Dermatoplasti- Saccaromyces cerevisiae
d) Sifonoplastul este caracteristic ciupercilor din clasa Phycomycetes. Este alcatuit din filamente simple sau ramificate, continui, fara pereti despartitori, care contin citoplasma si numerosi nuclei.
La ciupercile saprofite, sifonoplastul este alcatuit din formatiuni adaptate indeplinirii unor functii: rizoizi, sporangiofori, sporangi, stoloni(fig. 25).

Fig. 25 Sifonoplast- Rhyzopus nigricans-
a. sporange; b. sporangiofor; c. lumela; d. spori; e. rizoizi.
La ciupercile parazite sifonoplastul prezinta anumite prelungiri specializate in absorbtia elementelor nutritive, numite haustori(Plasmopara viticola, - fig. 26).



Fig. 26 Sifonoplast la ciuperci parazite- Plasmopara viticola
e) Talul filamentos este cel mai raspandit aparat vegetativ al ciupercilor. Acesta este este reprezentat de filamente multicelulare, simple sau ramificate, fiecare compartiment reprezentand o celula. Atat sifonoplastul cat si talul filamentos, mai sunt cunoscute sub numele de miceliu, iar filamentele care il alcatuiesc sunt numite hife miceliene. Talul filamentos este alcatuit la ciupercile din clasa Ascomycetes, la ordinul Ustilaginales si Uredinales(clasa Basidiomycetes) si la grupul Deuteromycetes(Nigrospora oryze), (fig.27).


Fig. 27 Tal filamentos- Nigrospora oryzae
f) Talul masiv este o impletire mai laxa sau mai densa, de taluri filamentoase ce da nastere unor false tesuturi numite plectenchime ( de absorbtie, de rezistenta, de conducere etc.). Acest tip de tal este caracteristic ciupercilor din clasa Basidiomycetes si unor ciuperci din clasa Ascomycetes. Sclerotii de Claviceps purpurea(fig. 28) prezinta in sectiune o portiune externa cu celule moarte, ingrosate, cu denumirea de paraplectenchim, iar in interior filamentele miceliene sunt intretesute mai lax, fiind alcatuite din celule vii, zona numita prosoplectenchim.




Inmultirea vegetativa se face prin fragmente de miceliu care, in conditii prielnice, reproduc ciuperca. Se cunosc si celule sau grupuri de celule cu membrana ingrosata care pot reproduce ciuperca pe cale vegetativa. Aceste celule poarta numele de artrospori (Oidium lactis), aleurospori(Aleurisma sp.) si blastospori (spori rezultati in urma inmuguririi dermatoplastilor ciupercilor din fam. Saccaromycetaceae).
Inmultirea asexuata are loc prin organe special diferentiate numite spori. Inmultirea prin spori reprezinta un stadiu din ciclul de viata al ciupercilor si se realizeaza in functie de conditiile de mediu (nutritie, temperatura, umiditate). Sporii joaca un rol important in raspandirea ciupercilor iar in unele cazuri pot indeplini si functii nespecifice de rezistenta sau sexualitate. Sporii sunt foarte variati ca forma , dimensiuni, numar de celule, loc de formare, etc.
Sporii se impart in doua categorii (dupa mobilitate):
- spori mobili (zoospori), ce prezinta unul sau doi flageli;
- spori imobili (aplanospori).
Dupa locul unde se formeaza deosebim:
- spori endogeni (endospori), formati in interiorul unor organe specielizate;
-spori exogeni(exospori), formati pe suporturi speciale.
Dintre sporii endogeni fac parte: sporangiosporii(se formeaza in sporangi) si ascosporii(se formeaza in asce in urma procesului de sexualitate).
Ca spori exogeni, mentionam conidiile formate pe conidiofori si bazidiosporii(formati pe epibazidii sau promiceliu).
Ciupercile din clasa Ascomycetes se inmultesc asexuat prin zoospori(Synchitryum endobioticum) sau aplanospori(Plasmodiophora brassicae), formati prin transformarea intregului aparat vegetativ intr-un organ sporifer.
Ciupercile din clasa Phycomycetes se inmultesc asexuat prin aplanospori endogeni sau prin zoospori ce apar in zoosporangi caduci numiti metasporangi. Ortosporangii se pot observa la ciuperca Pythium de Baryanum(fig. 29).




Fig. 30 Metasporangi- Albugo candida
Ciupercile din clasa Ascomycetes grupul Deuteromycetes si partial din clasa Basidyomycetes (ordinul Uredinales) se inmultesc asexuat prin conidii, spori exogeni si caduci, formati pe conidiofori. La maturitate, conidiile se desprind de pe conidiofor, germineaza si dau nastere unui tal filamentos.
Dupa aspectul morfologic al conidiilor, deosebim trei tipuri:
a) hifal - conidii ce apar pe conidiofori aerieni. Acest tip de conidii se observa la Oidium farinosum(fig. 31) care produc fainarea la mar, precum si la Botrytis fuckeliana(fig. 32), ce produc putregaiul cenusiu al strugurilor;
b) melanconial- conidii ce apar pe conidiofori scurti, grupati in lagare numite acervuli. In frunza atacata de ciuperca Gloeosporium juglandis(fig. 33), se observa, in sectiune, acervuli adanciti in substrat, ce contin conidii de forma semilunara;
c) sferopsidal- conidii ce apar in fructificatii(picnidii) formate in tesutul infectat. Aceste conidii se mai numesc si picnospori.
Intr-o sectiune efectuata prin frunza de grau atacata de ciuperca Septoria tritici(fig. 34), se observa picnidii globuloase ce contin numerosi picnospori multicelulari, filamentosi de culoare galbuie.


Fig. 31 Conidii de tip hifal Fig. 32 Conidii de tip hifal
Oidium farinosum Botrytis fuckeliana


Fig. 33 Conidii de tip melanconial Fig. 34 Conidii de tip sferopsidal
Gloesporium juglandis Septoria tritici
Conidiile sunt de regula sensibile la factorii climatici nefavorabili si din aceasta cauza ciclul de dezvoltare al ciupercilor din clasa Ascomycetes si Basidiomycetes este reluat in primavara de catre ascospori si respectiv, bazidiospori.
Acest tip de inmultire presupune existenta sau parcurgerea a doua procese: fecundarea si reducerea cromatica.
Procesul de fecundatie consta in unirea a doua celule ce joaca rol de gameti, in cursul a doua etape:
plasmogamia- sau fuzionarea celor doua mase citoplasmatice ale gametilor;
cariogamia- sau contopirea celor doi nuclei, in urma careia se formeaza un nucleu diploid.
La ciuperci, aceeasi celula joaca atat rolul de celula zeugit(in care are loc cariogamia) cat si rolul de celula gonotocont(unde are loc reducerea cromatica).
Produsul de sexualitate se numeste zigozoospor. La Synchytrium endobioticum
Zigozoosporul se transforma intr-un spor de rezistenta numit akinetosporange(fig. 34). El este poliedric, colturos, galben-brun, invelit intr-o membrana tristratificata. Din akinetosporangi prin germinare apar zoosporii.




Fig. 35 Akinetosporange

Fig. 36 Zigot
Mucor hiemalis
Produsul final al procesului sexuat de inmultire se numeste zigot.
Ciupercile de Mucor hiemalis formeaza zigoti de culoare neagra, cu suprafata rugoasa(fig. 35).
Ciupercile din clasa Phycomycetes ordinul Oomycetales prezinta doua gametangii diferentiate ca forma: gametangiul mascul numit anteridie si cel femel numit oogon. Procesul sexuat este o heterogametangiogamie sau oogamie iar produsul final oospor.
Ca exemplu: in frunza de mohor atacata de Sclerospora graminicola se formeaza numerosi oospori, de culoare galbuie, de forma sferica, cu membrana ingrosata, dispusi in straturi paralele(fig.37).

Fig. 37 Oospori
Sclerospora graminicola
La majoritatea ciupercilor din clasa Ascomycetes, procesul de fecundatie este mult simplificat in sensul regresiei gametangiilor si preluarii functiilor acestora de catre celulele vegetative. Acest proces sexuat poarta numele de somatogamie.
-loculi- fara perete propriu, formate in stroma ciupercii;
-cleistotecii- cu perete propriu, complet inchise- sunt puse in libertate prin putrezirea peretelui;
-peritecii-au perete propriu si sunt prevazute cu un por pentru eliminarea ascei;
-apotecii- cu perete propriu in forma de disc, cupa, palnie, taler etc. peretii interiori sunt tapetati cu asce.
In figura 39 se observa, intr-o sectiune efectuata prin tulpina de grau atacata de Ophiobolus graminis, loculi in stroma.
Pe frunzele de grau atacate de Erysiphe graminis apar puncte mici, negre care sunt cleistotecii(fig. 40).
Intr-o sectiune prin ascostroma care rezulta prin germinatia sclerotului Claviceps purpurea se observa mai multe peritecii dispuse radiar, pe un singur rand cu porul de eliminare al ascelor orientat spre exterior(fig. 40).
Din sclerotii de la ciuperca Sclerotinia sclerotiorum(fig. 41), rezulta prin germinare apotecii in forma de palnie, larg deschise. Intre asce se observa filamente sterile numite parafize cu rol in protejarea ascelor pana la maturitate.

Fig. 38 Asce libere Taphrina deformans

Fig. 39 Loculi in stroma
Gäumannomyces graminis



Fig. 40 Cleistotecie Erysiphe graminis


Fig. 41 Peritecie
Claviceps purpurea

Fig. 42 Apotecie- Sclerotinia sclerotiorum
Ciupercile din clasa Basidiomycetes prezinta un proces de inmultire simplificat numit somatogamie. Procesul de plasmogamie are loc intre doua celule haploidale ale miceliului primar, diferentiate ca sex, prin simpla disparitie a peretelui despartitor. In urma plasmogamiei rezulta miceliul secundar, parazit in dicariofaza si de lunga durata. Acesta isi incheie vegetatia cu formarea bazidiei, ca ultim produs de sexualitate.
Ciupercile din ordinul Uredinales prezinta bazidii sclerificate numite clamidospori.
Procesul de plasmogamie are loc intre doua sporadii prin intermediul unui canal de conjugare(Tilletia sp.- fig.43).

Fig. 43 Sporadii conjugate- Tilletia sp
Ciupercile din ordinul Uredinales formeaza pe miceliul secundar, imediat dupa plasmogamie fructificatii numite ecidii in care se formeaza ecidiospori. Dupa forma ecidiile pot fi de patru tipuri: cupa, mamelon, dezvoltata peste lanturile de ecidiospori, cu deschidere prin por, larg deschisa(fig. 44).
In frunza de Berberis vulgaris se formeaza in cazul infectiei cu Puccinia graminis, f. Sp. tritici, picnidii si ecidii in forma de cupa(fig. 44).
Intr-o alta etapa de dezvoltare, ulterioara, pe miceliul secundar al ciupercilor din ordinul Uredinales se formeaza pustule(lagare) cu uredospori sesili sau

Fig. 44 Ecidii
pedunculati, binucleati. Ultimul produs de sexualitate-bazidia sclerificata, se numeste teleutospor.
Ciupercile care au toate cele cinci tipuri de spori(bazidiospori, picnospori, ecidiospori, uredospori si teleutospori) se numesc macrociclice, iar celelalte microciclice.
Ciupercile care formeaza sporii pe o singura planta gazda se numesc autoice iar cele care paraziteaza doua sau mai multe plante sunt numite heteroice.



|